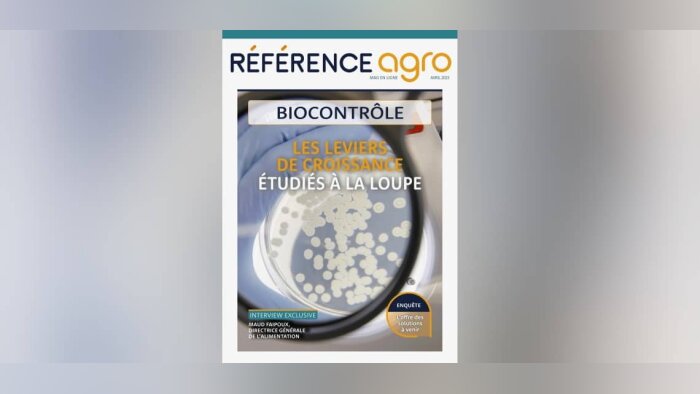

Insecticides de biocontrôle, Syngenta et Biotalys s’associent
Syngenta et Biotalys annoncent le 24 avril 2023 un partenariat stratégique pour développer, rechercher et commercialiser des insecticides de biocontrôle. Syngenta Crop Protection et Biotalys, start-up belge créée en 2013 en tant que spin-off du...

Affichage environnemental, écoscore : mobilisation générale !
Alors que l’Europe a fait marche arrière sur l’affichage environnemental des produits biosourcés, la France accélère pour hisser le drapeau tricolore de l’écoscore sur le Vieux continent. Les centres techniques appellent les entreprises et...

Biocontrôle, des délais français d’évaluation déjà optimisés
Selon l’Anses, l’accélération de la mise en marché des produits de biocontrôle viendra désormais essentiellement de l’Europe, avec une priorisation du calendrier d’approbation des substances actives. En France, évaluateurs et décisionnaires sont...

Avec DIGI.DOCS.AGRI, Adama accompagne les utilisateurs de ses produits dans la mise en oeuvre des traitements
ADAMA lance les Digi.Docs.Agri, 3 documents connectés résumant l’essentiel des règlements à connaître avant, pendant et après un traitement. Avec deux objectifs : simplifier et sécuriser. ADAMA s’engage comme partenaire des agriculteurs face aux...

Carroussel et Constel, les orges brassicoles tolérante à la JNO les mieux référencées par les industriels
Dans une micro-brasserie dijonnaise le 12 avril dernier, en ouverture du Colloque annuel d’Arvalis sur les orges brassicoles, SECOBRA Recherches avait invité de nombreux acteurs de la filière orge-malt-bière. L’obtenteur, bien connu pour ses...

Moral des TC, eau, fertilisants
Au menu de ce nouveau numéro de l’Agro s’écoute, découvrez pourquoi les technico-commerciaux se sentent dévalorisés, quelle entreprise française a été notifiée pour certifier les fertilisants au niveau européen, les enjeux du dossier « eau et...
Mag biocontrôle 2023, les dix infos à retenir
En 35 pages, l’édition 2023 de notre Mag dédié au biocontrôle fait le tour de tous les acteurs impliqués dans le déploiement de ces solutions alternatives aux produits conventionnels. Actualités, perspectives… les informations sont légion. Nous...

S-métolachlore, l’Anses acte les retraits
Malgré la volonté du Gouvernement de s’inscrire dans un calendrier européen, l’Anses a, le 20 avril 2023, acté le retrait de produits et d’usages de produits phytosanitaires contenant du S-métolachlore. La fin des ventes est fixée au...
De Sangosse acquiert une part de Kan Biosys pour développer ses biosolutions en Inde.
Dans un communiqué de presse du 21 avril, De Sangosse annonce acquérir une partie stratégique de la firme indienne Kan Biosys India Private Limited, un acteur reconnu des technologies à base de micro-organismes en Inde.Kan Biosys dispose de...

Avril publie des résultats records
Le groupe Avril a présenté, le 19 avril, un bilan financier 2022 très positif. Si l’année 2023 s’annonce plus compliquée, l’entreprise mise sur sa bonne santé, la résilience de son modèle et ses choix stratégiques pour saisir de nouvelles...

Green Impulse veut passer à la phase d’industrialisation
Créée en 2019, la start-up présente sur le secteur du biocontrôle Green Impulse entend passer à la vitesse supérieure pour commercialiser ses produits en France. La start up Green Impulse veut passer à la phase d’industrialisation. Créée en 2019...

Les projets de décarbonation de l’industrie se poursuivent
Six mois après le lancement, par Emmanuel Macron, de la consultation des dirigeants des sites les plus polluants du pays, Référence agro a voulu savoir où en était la feuille de route des entreprises concernées. Producteurs d’engrais et acteurs...

Cérèsia présente une ambitieuse feuille de route stratégique
Le 18 avril, Cérèsia a présenté ses axes de développement stratégiques. Quatre ans après la fusion entre Cerena et Acolyance, qui a vu naître la coopérative, cette dernière compte améliorer ses performances économiques, se protéger des aléas...

Découvrez librement et simplement le référentiel HVE grâce à l’outil en ligne Diagagroeco
Dans la poursuite de la mise au point d’outils d’accompagnement des agriculteurs pour la mise en œuvre volontaire de l’agroécologie, DIAGAGROECO outil de diagnostic agroécologique des exploitations agricoles, développé par l’Acta avec l’appui du...

Lutte contre le mildiou : Mileos s’intègre dans des OAD partenaires
Le modèle de gestion du risque mildiou de la pomme de terre d’ARVALIS, qui a fait le succès de Mileos.fr, est désormais intégré dans différents outils d’aide à la décision (OAD). Il est ainsi accessible à un plus grand nombre d’utilisateurs pour...

Du nouveau dans l’équipe d’Arvalis
Le colloque de la filière orges brassicoles a été l’occasion, pour Arvalis, de présenter sa nouvelle équipe dédiée à cette production. Philippe Dubief (photo), vice-président de l’AGPB, prend la suite de Didier Lenoir à la présidence de la...